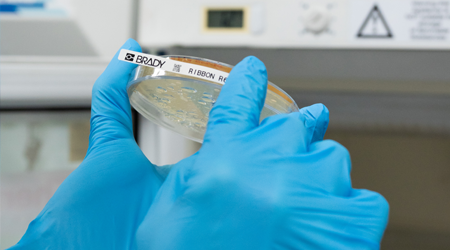

RFID etikety pro sledování a správu majetku
Spolehlivé RFID etikety
Díky spolehlivým pasivním, bezbateriovým RFID etiketám od společnosti Brady lze každému majetku přidělit jedinečnou digitální identitu. Tuto jedinečnou identitu lze přečíst automaticky, na dálku, bez nutnosti přímé viditelnosti.
Majetek, výrobky, součástky a kabely opatřené RFID etiketami budou okamžitě čitelné pro automatizované aplikace Internetu věcí nebo Průmyslu 4.0. Řízení zásob, inventurní audity, kontroly nákladu, stav výroby, viditelnost dodavatelského řetězce: to vše lze snadno automatizovat, pokud své položky vybavíte správnou RFID etiketou vhodnou pro váš obchodní kontext.
Přizpůsobitelné RFID etikety dávají každému majetku a výrobku jedinečnou digitální identitu a umožňují efektivnější sledování a správu majetku a výrobků v mnoha různých průmyslových prostředích. Ve společnosti Brady navrhneme řešení RFID značení na míru, které nejlépe vyhoví vašim potřebám, a to včetně antény, čipu, materiálu etiket, lepidla a potisku. Pojďme se podívat na naše na míru přizpůsobitelné RFID etikety a najít to správné řešení pro vaši firmu.
Proč značka Brady?
Se společností Brady jako partnerem lze pomocí RFID etiket spolehlivě identifikovat jakýkoli předmět v téměř jakémkoli kontextu. Využíváme více než stoletou zkušenost s materiály etiket a celosvětové zkušenosti v náročných průmyslových odvětvích, abychom vám dodali ty nejspolehlivější RFID etikety pro vaši aplikaci.

Spolehlivé RFID etikety
Naše pasivní RFID etikety jsou vyrobeny z nejspolehlivějších a praxí prověřených materiálů.
〉Kontaktujte nás
Přizpůsobitelné RFID etikety na míru
Jedinečné výzvy mohou vyžadovat jedinečné RFID etikety. Proberte své potřeby s našimi odborníky.
〉Přizpůsobte si své RFID etikety
Vyberte si RFID etikety
Jak vybrat nejlepší RFID etikety pro svou firmu? Než se rozhodnete, poraďte se s našimi odborníky.
〉Vyberte si RFID etiketyCo jsou RFID etikety?
RFID etiketa (etiketa pro radiofrekvenční identifikaci) využívá rádiové vlny k bezdrátovému přenosu informací s jinými zařízeními.
Tyto informace mohou zahrnovat název položky, typ, cenu, umístění nebo pouze jedinečný kód EPC etikety, který propojí jakýkoli majetek s příslušnými informacemi v databázích. Za tímto účelem mají RFID etikety malý počítačový čip a malou anténu, které jsou zcela zabudovány do etikety.
RFID etikety lze tisknout stejně jako tradiční etikety s čárovým kódem a poskytují zajímavé další výhody. Lze je číst bezdrátově, na dálku, bez nutnosti přímé viditelnosti. Jediná čtečka RFID dokáže každou sekundu přečíst tisíce RFID etiket najednou. Informace ukládané a/nebo přenášené RFID etiketami lze aktualizovat v reálném čase. Díky tomu jsou RFID etikety ideální pro řízení zásob, sledování majetku, přehled o výrobě, ochranu proti krádeži a bezpečnostní aplikace.
Frekvence RFID etiket
Stejně jako kterýkoli jiný systém využívající rádiové vlny pracují i RFID etikety na určitých rádiových frekvencích. Obecně platí, že RFID etikety s nižší frekvencí mají nižší rychlost čtení dat a menší dosah, zatímco RFID etikety s vyšší frekvencí lze číst rychleji a na větší vzdálenost.
Na druhou stranu je však rušení rádiových vln kovy a kapalinami vyšší u vysokofrekvenčních RFID etiket a nižší u nízkofrekvenčních RFID etiket.

Nízkofrekvenční RFID etikety
Nízkofrekvenční RFID etikety (LF) pracují v nízkofrekvenčním elektromagnetickém spektru od 30 do 300 KHz. Nízkofrekvenční RFID etikety obvykle pokrývají 125 až 134 kHz. To znamená, že štítky se čtou rychlostí 125 000 až 134 000 rádiových vln za sekundu. Nízkofrekvenční RFID etikety, které se často používají pro kontrolu přístupu, mají nejkratší dosah čtení, obvykle do 10 cm, a nejpomalejší rychlost čtení. Současně nízkofrekvenční RFID etikety nabízejí minimální rušení kovy a kapalinami.

Vysokofrekvenční RFID etikety
Vysokofrekvenční RFID etikety (HF) pracují ve vysokofrekvenčním elektromagnetickém spektru od 3 do 30 MHz, obvykle na frekvenci 13,56 MHz. Jejich čtení probíhá rychlostí 13,56 milionu rádiových vln za sekundu. Vysokofrekvenční RFID etikety mají obvykle dosah čtení 3 až 10 cm a používají se při přenosu dat, včetně platebních terminálů s komunikací v blízkém poli (NFC).

Ultra-vysokofrekvenční RFID etikety
Ultra-vysokofrekvenční RFID etikety (UHF) se nacházejí v ultra-vysokofrekvenčním elektromagnetickém spektru mezi 300 MHz a 3 GHz. Pracují na frekvenci 433 MHz (aktivní, bateriové RFID etikety) nebo 860–960 MHz (pasivní, bezbateriové RFID etikety). UHF RFID etikety poskytují nejrychlejší přenos dat a nejdelší čtecí vzdálenost.
Aktivní – pasivní RFID etikety
Ultra-vysokofrekvenční RFID etikety (UHF RFID etikety) lze rozdělit do dvou hlavních kategorií: aktivní RFID etikety, které jsou napájeny baterií, a pasivní RFID etikety, které jsou bezbateriové.
Aktivní neboli bateriové RFID etikety mají obecně větší čtecí vzdálenost a neustále vysílají signál. Jelikož obsahují baterii, jsou objemnější a náročnější na údržbu. Pasivní neboli bezbateriové RFID etikety jsou menší, cenově dostupnější a mohou každou sekundu odrážet signály ze čteček RFID.

Pasivní RFID etikety
Pasivní RFID etikety nemají vnitřní zdroj napájení. Místo toho přijímají elektromagnetickou energii ze čteček RFID v nastavitelných intervalech. Díky nižší ceně a delší životnosti jsou užitečné v široké škále aplikací, včetně kontroly přístupu, sledování majetku, řízení zásob, viditelnosti dodavatelského řetězce a bezpečnostních aplikací. Obvykle jsou opatřeny lepicí vrstvou a lze je snadno umístit na mnoho různých předmětů.
Pasivní, bezbateriové RFID etikety
- většinou používají frekvenční rozsah 865–868 MHz (ETSI – Evropský ústav pro telekomunikační normy – Evropská unie) nebo frekvenční rozsah 902–928 MHz (FCC – Federální komise pro komunikace – Spojené státy americké)
- mají čtecí dosah 0 až 25 metrů
- mají nižší náklady na etikety a vyšší náklady na infrastrukturu (více čteček RFID)

Aktivní RFID etikety
Aktivní, bateriové RFID etikety fungují jako maják a využívají vnitřní zdroj energie k nepřetržitému vysílání signálu. Aktivní RFID etikety se obvykle vyměňují každé 3 až 4 roky, když se jim vybije baterie. Používají se v prostředích, kde je obtížnější umístit čtečky RFID, například pro sledování přepravy.
Aktivní, bateriové RFID etikety
- využívají frekvenční rozsah 433 MHz
- mají čtecí dosah 30 až 100 metrů
- mají vyšší náklady na etikety a nižší náklady na infrastrukturu (méně čteček RFID)
- mohou pro ně platit přepravní omezení kvůli jejich bateriím
Shoda RFID etiket s předpisy
RFID etikety musí splňovat řadu předpisů. Ty se mohou v jednotlivých regionech nebo zemích lišit a mohou upravovat frekvenci rádiových vln a certifikaci vyráběných nebo dovážených zařízení. Některé země také regulují, kde lze RFID používat nebo jak rychle by měly aplikace RFID přeskakovat frekvence v rámci přiděleného frekvenčního rozsahu.

Frekvence RFID etiket
Rádiové frekvence jsou regulovány, aby se omezilo rušení mezi rádiovými aplikacemi, včetně leteckých přenosů, satelitních komunikací a komunikací pro první pomoc. V Evropské unii řídí vyhovující frekvence ETSI (Evropský ústav pro telekomunikační normy), ve Spojených státech FCC (Federální komise pro komunikace). Normy ETSI a FCC byly zavedeny i v jiných zemích, někdy s úpravami.

Certifikace RFID etiket
Mnoho zemí vyžaduje certifikaci používaných, vyráběných a dovážených systémů RFID, včetně RFID etiket. Dokonce i pasivní RFID etikety mohou podléhat certifikaci, ve většině případů předtím, než je lze použít pro konkrétní aplikace nebo prostředí. Mezi běžné certifikace patří například ISO, GS1, ARC, ATEX, IECEx, UL, IP, IK a speciální průmyslové normy v automobilovém a leteckém průmyslu.
Složení RFID etiket
Každá RFID etiketa se skládá z několika součástí, které jí umožňují přijímat a vysílat rádiové signály, zpracovávat informace, držet na předmětu a zůstat funkční.

Svrchní vrstva RFID etiket
Na potisknutelný povrch našich RFID etiket lze nanášet vysoce odolný termotransferový potisk, včetně drobných a dobře čitelných 2D kódů. Svrchní vrstvy upravují vlastnosti podkladu etiket, jako je odolnost vůči venkovním vlivům, ohni, teplu nebo chemikáliím. Kromě toho svrchní vrstva definuje také matný nebo lesklý povrch etiket.

Podklad RFID etiket
Podkladový materiál RFID etikety rozhoduje o odolnosti etikety vůči různým faktorům v kontextu daného účelu použití. Chrání anténu a čip RFID etikety. Papírové etikety jsou sice velmi rozšířené, ale nefungují dobře ve venkovním prostředí, na zakřivených plochách nebo při vystavení oděru, chemikáliím a teplotám používaným v mnoha průmyslových procesech.

Anténa RFID etiket
Anténa RFID etikety přijímá signály ze čtečky RFID a odesílá data zpět. Optimální antény RFID etiket se liší velikostí, tvarem a konstrukcí v závislosti na prostředí, ve kterém budou použity, na podkladu RFID etikety a na čipu RFID etikety. Anténa RFID etiket a čip RFID etikety tvoří společně vložku RFID etikety.

Čip RFID etikety
Čip nebo integrovaný obvod RFID etikety obvykle obsahuje 4 paměťové bloky, které obsahují informace o označeném předmětu nebo o samotné RFID etiketě. Do elektronického kódu výrobku (EPC) a uživatelského paměťového bloku lze naprogramovat jedinečné číslo a informace o označeném majetku. Identifikátor štítku (TID) obsahuje jedinečné číslo etikety přidělené výrobcem, a rezervovaný paměťový blok lze použít pro speciální účely použití RFID etiket.

Snímač RFID etiket
Snímač RFID etiket může být volitelně součástí bezbateriových UHF RFID etiket. Tyto speciální snímače jsou napájeny čtečkami RFID v přizpůsobitelných intervalech, stejně jako čip RFID etikety a anténa RFID etikety. Lze začlenit různé snímače pro snímání údajů o prostředí majetku, jako je teplota, vlhkost, tlak a další.

Vlastní vrstva RFID etiket
Rádiové frekvence jsou regulovány, aby se omezilo rušení mezi rádiovými aplikacemi, včetně leteckých přenosů, satelitních komunikací a komunikací pro první pomoc. V Evropské unii řídí vyhovující frekvence ETSI (Evropský ústav pro telekomunikační normy), ve Spojených státech FCC (Federální komise pro komunikace). Normy ETSI a FCC byly zavedeny i v jiných zemích, někdy s úpravami.

Lepidlo RFID etiket
Lepidlo RFID etiket drží etiketu na konkrétním povrchu předmětu nebo majetku, což je v každém řešení sledování a dohledávání zcela zásadní. Společnost Brady poskytuje lepidla na bázi akrylu, pryže a silikonu v závislosti na podkladu a prostředí, ve kterém se RFID etikety používají.

Podkladový pás RFID etiket
Samolepicí RFID etikety se uvolňují pomocí tenkých nosičů – podkladového pásu etiket. Obvykle se vyrábí ze silikonizovaného papíru, ale společnost Brady nabízí také PET podkladové pásy etiket pro minimalizaci prašnosti při speciálních účelech použití.
Vedle pružných samolepicích RFID etiket vyrábí společnost Brady také pevné a pružné RFID štítky a RFID karty a jmenovky bez lepicí vrstvy.
Typy RFID etiket
Aby bylo možné optimálně reagovat na poptávku po aplikacích RFID v mnoha průmyslových odvětvích, byla vyvinuta bohatá škála RFID etiket. RFID etikety lze rozdělit do kategorií několika způsoby a v jedné RFID etiketě lze s určitými omezeními kombinovat více aspektů. RFID etikety lze rozdělit do různých kategorií:
- podle druhu: RFID etikety, RFID vlaječkové etikety, pevné RFID štítky, pružné RFID štítky, RFID karty, RFID jmenovky
- podle frekvence: nizkofrekvenční (LF), vysokofrekvenční (HF nebo NFC: komunikace v blízkém poli), ultra-vysokofrekvenční (UHF)
- podle povrchu: RFID etikety na nekovové povrchy, RFID etikety na kovové povrchy, kabelové RFID etikety
- podle vylepšení: RFID etikety se snímáním teploty, etikety se snímáním vlhkosti, LED etikety RFID
- podle prostředí: RFID etikety odolné proti oděru, RFID etikety odolné proti vodě, robustní RFID etikety, RFID etikety odolné proti vysokým teplotám, RFID etikety odolné proti chemikáliím
- podle materiálu etiket: polyesterové RFID etikety, polypropylenové RFID etikety, papírové RFID etikety
Spolehlivé RFID etikety
Společnost Brady nabízí širokou škálu spolehlivých RFID etiket, které jsou k dispozici jako standardní díly. Všechny naše RFID etikety jsou pasivní (bezbateriové) a jsou napájeny ze čteček RFID.
UHF RFID etikety
Čtení více štítků najednou, na dálku,
bez nutnosti přímé viditelnosti.
HF/NFC RFID etikety
Snadný přístup k informacím o označeném majetku
a jejich aktualizace pomocí chytrého telefonu.
RFID etikety s dvojí frekvencí
Spojení výhod technologií
UHF a NFC v jedné etiketě.
Samolepicí RFID etikety
Snadné přidělení jedinečné digitální identity majetku
přitisknutím etikety na jeho povrch.
Textilní RFID etikety
Pružné, snadné, nenápadné a účinné. Zažehlete
jedinečnou digitální identitu do jakéhokoli textilu.
Pevné RFID štítky
Odolávejte nejnáročnějším okolnostem
s pevnými RFID štítky přišroubovanými k majetku.
Vlaječkové RFID etikety
Naše vlaječkové RFID etikety, které jsou ideální pro sledování,
dohledávání a lokalizaci kabelů, pevně drží na jakémkoli kabelu.
Etikety RFID pro nekovové povrchy
Maximalizujte dosah pomocí spolehlivých RFID etiket
na karton, dřevo, plast, sklo a další povrchy.
Etikety RFID pro kovové povrchy
RFID etikety pro kovové povrchy jsou opatřeny vlastní
vrstvou, která zabraňuje rušení kovem.
RFID etikety se snímáním teploty
Sledování teploty položek pomocí pasivních
RFID etiket se snímáním teploty.
RFID etikety se snímáním vlhkosti
Pomocí pasivních RFID etiket se snímáním vlhkosti lze
z centrálního místa zjistit mokrý/suchý stav předmětu.
LED etikety RFID
Méně hledejte, najděte více. Využijte naše LED etikety RFID
pro kabely a ploché povrchy k vychystávání pomocí světelné navigace.
Přizpůsobitelné RFID etikety na míru
Jako zkušený integrátor a výrobce dokáže společnost Brady přizpůsobit jakoukoli součást výrobku tak, aby zefektivnila nebo umožnila náročné aplikace RFID. Zvyšte přínosy svého řešení RFID na maximum tím, že plně využijete naše výrobní schopnosti. Nechte naše odborníky navrhnout RFID etiketu na míru, která bude optimálně vyhovovat vašemu provozu a vašemu prostředí.

Optimalizovaný čtecí dosah RFID etiket
Do naší široké nabídky osvědčených a prověřených etiket můžeme začlenit pasivní UHF a NFC antény RFID. Díky naší technologické flexibilitě vám můžeme nabídnout přesně vyladěné čtecí dosahy a velikosti etiket, které optimálně vyhoví vašemu účelu použití.
Zaměřeno na vaše údaje
Naši specialisté na RFID mohou do vašich RFID etiket začlenit mikročipy s těmi nejvhodnějšími paměťovými bloky. Většina aplikací RFID pracuje s univerzálními čipy RFID, pro některé jsou však potřeba větší paměťové bloky.
Maximální spolehlivost RFID etiket
Vědci ze společnosti Brady navrhují etikety pro maximální spolehlivost ve speciálních aplikacích. Vybíráme svrchní vrstvy etiket, podklady, lepidla a vložky tak, abychom nabídli RFID etikety, které budou v průmyslových aplikacích a prostředích pevně držet.
Možnost tisku na vašem pracovišti
Můžeme naprogramovat předtištěný spotřební materiál pro RFID etikety tak, aby bylo možné přidat tisk na přesné místo pomocí tiskárny Brady přímo na vašem pracovišti. Prázdné potisknutelné a kódovatelné RFID etikety jsou k dispozici jako standardní díly.
Výběr správné RFID etikety
Optimální RFID etiketu pro konkrétní aplikaci v konkrétním kontextu je nejlepší konzultovat s odborníky na RFID. Společnost Brady bere v úvahu širokou škálu faktorů, aby zákazníkům pomohla s výběrem RFID etiket, které jim přinesou maximální hodnotu na pracovišti.
Obraťte se na odborníkaČtecí dosah RFID etikety
❯ Frekvence RFID etikety
Frekvence, na které bude etiketa RFID pracovat, spoluurčuje její čtecí dosah. Ultra vysoké frekvence obvykle nabízejí čtecí dosah více než 10 metrů. Vysokofrekvenční RFID etikety mají obvykle čtecí dosah až 10 cm a nízkofrekvenční RFID etikety mají nejkratší čtecí dosah.
❯ Velikost RFID etikety
Zlaté pravidlo říká, že čím větší je etiketa, tím delší je čtecí dosah. Větší vložené antény RFID umožňují delší čtecí dosah. Etiketa musí být o něco větší než vložka, aby se do ní vložka správně vešla a byla dobře chráněna.
❯ Typ RFID etikety
Pro identifikaci kovových povrchů nebo nádob s kapalinami je velmi důležitá volba správného typu RFID etikety. Díky izolační vrstvě nebo tvaru vlaječky mohou RFID etikety maximalizovat čtecí dosah, a to i v případě rušení kovy a kapalinami.
Podklad RFID etikety
Vždy se poraďte ohledně majetku, součástí, kabelů nebo předmětů, které chcete sledovat pomocí RFID. V závislosti na povrchu předmětu se volí různá lepidla, způsoby montáže a dokonce i tvary RFID etiket, aby byla zajištěna co nejvyšší účinnost. Budou RFID etikety aplikovány na mokrý povrch? hrubý nebo hladký povrch? Mají se používat na kovy, plasty, sklo nebo jiné typy povrchů?
Prostředí RFID etikety
Pro dosažení maximální spolehlivosti by měly být zvoleny takové RFID etikety, které jsou odolné vůči prostředí, kde se používají. Patří sem vystavení (extrémním) teplotám, chemikáliím, oděru, UV záření, vlhkosti nebo nečistotám. V závislosti na těchto faktorech lze zvolit optimální materiál etiket pro ochranu vložky RFID s anténou RFID a čipem.
Údaje na RFID etiketě
Množství údajů, které bude potřeba při daném účelu použití zapsat, určuje typ čipu obsaženého ve vložce RFID etikety. Pro většinu aplikací RFID lze použít univerzální čipy RFID. U některých aplikací jsou vyžadovány čipy s velkou uživatelskou pamětí.
Kompatibilita RFID etikety
Při výběru optimální RFID etikety vezměte v úvahu hardware, který může vaše aplikace potřebovat. Chcete tisknout a programovat RFID etikety přímo na svém pracovišti? Budete používat chytré telefony, přenosné čtečky RFID, pevné čtečky RFID nebo jejich kombinace?